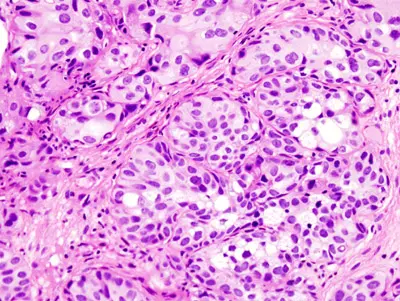

At the German Cancer Research Center (Deutsches Krebsforschungszentrum, DKFZ), a team of scientists headed by Dr. Rajiv Kumar recently discovered a common gene mutation in malignant melanoma. This mutation affects telomerase, an enzyme often called the “immortality enzyme". In order to unravel the role of this gene mutation in other types of cancer, the investigators have collaborated with colleagues from the Karolinska Institute in Sweden to analyze the genomes of tumors from 327 patients with bladder cancer. They discovered identical alterations in 65 percent of the tumors.
Telomerase protects the ends of chromosomes from being lost during the process of cell division and thus prevents the cell from aging and dying. If patients inherit a mutation in the gene, a new binding site for protein factors forms in the controlling region (promoter) of the telomerase gene, causing it to become overactive. As a result, mutated cells overproduce telomerase and become virtually immortal.
Patients whose tumor genome exhibits the mutation have a less favorable course of the disease, and the cancer recurs more often after treatment. However, this does not hold true universally, but only in cases where a specific, additional “spelling variation" is found at a different site of the telomerase gene switch. Such alternative spelling variations at individual positions of the genome are called polymorphisms.
Only patients who exhibited the most common, “normal" variant experienced the adverse effect of the telomerase mutation. By contrast, it was barely noticeable in carriers of the alternative version that occurs more rarely. The researchers suspect that the rarer variant cancels the activating effect of the first mutation on the telomerase.
Rajiv Kumar believes that cells with the activating mutation in the telomerase promoter are in a stronger position when cancer develops: “They are dividing frequently, so tumor cells depend on telomerase to keep their genetic material intact."
The role of the telomerase in cancer cells opens up new approaches toward treating bladder cancer with novel drugs. Substances inhibiting telomerase have already been developed and some are currently being tested in phase III clinical trials. Inhibiting the immortality enzyme might also arrest growth in cases of bladder cancer that have already arisen. Kumar and his colleagues additionally think that this combination of mutation and gene variant will serve as a promising biomarker in predicting the course of a disease.
Researchers discovered the mutation in the telomerase promoter in 65 percent of cases of bladder cancer, in 74 percent of cases of melanoma, and in 83 percent of cases of glioblastoma. “Most genome analyses focus the search for cancer-promoting mutations on the protein-coding areas of the genome," Kumar says. “This explains why it has taken so long to discover this extremely common mutation."
P. Sivaramakrishna Rachakonda, Ismail Hosen, Petra J. de Verdier, Mahdi Fallah, Barbara Heidenreich, Charlotta Ryk, Peter Wiklund, Gunnar Steineck, Dirk Schadendorf, Kari Hemminki and Rajiv Kumar: TERT promoter mutations in bladder cancer affect patient survival and disease recurrence through modification by a common polymorphism. Proceedings of the National Academy of Sciences, USA, 2013, DOI: 10.1073/pnas.1310522110